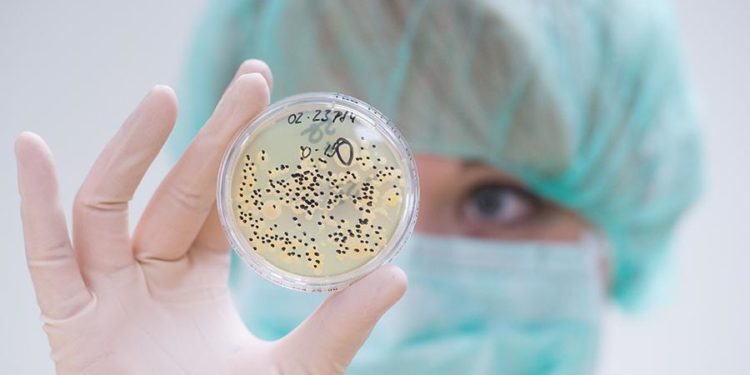
Индийская "черная плесень" уже добралась до России

Индийская "черная плесень" уже добралась до России
В РФ выявлены зараженные мукормикозом на фоне COVID-19
Фото: ТАСС
В России зафиксированы случаи заражения пациентов с COVID-19 опасной "черной плесенью", которая на фоне обострения ситуации с коронавирусом широко распространилась в Индии. Об этом сообщает Cronos.asia со ссылкой на "Известия".
Речь о мукормикозе — редкой грибковой инфекции, которую вызывают микроскопические грибы (мукормицеты), распространенные повсеместно. Они обитают в почве, их часто выделяют на поверхности гниющих растений и овощей.
Эта инфекция поражает нос, глаза и органы дыхания. Болезнь развивается в полости носа и придаточных пазухах, а также вторично распространяется в глазницы. На пораженных участках из-за некроза ткани возникает характерный черный струп, особенно выраженный на коже в области носа. Без лечения грибок может привести к скоропостижной смерти зараженного, а при терапии спасти удается только половину пациентов.
Эту проблему нельзя назвать чисто индийской, так как заболевание встречается во всех странах, и Россия не исключение, сообщил завкафедрой клинической микологии, аллергологии и иммунологии СЗГМУ им. И.И. Мечникова Николай Климко.
"В нашей стране мукормикоз встречается редко, преимущественно у онкогематологических пациентов. Ничего сравнимого с ситуацией в Индии в России сейчас нет. Насколько я знаю, были только единичные случаи мукормикоза у больных COVID-19. Сейчас один такой пациент лечится в нашей микологической клинике, надеюсь, у него всё будет хорошо", — сказал ученый.
Однако исключать возможность заражения ряда пациентов нельзя, уточнил он. В первую очередь мукормикоз опасен для людей с подавленным иммунитетом, отметил специалист. У больных COVID-19 инфекция развивается обычно на фоне декомпенсированного сахарного диабета, рассказал Николай Климко. В Индии заболеваемость высока именно из-за большого количества пациентов с этим недугом.
Подписывайтесь на Telegram-канал Central Asia Cronos и первыми получайте актуальную информацию!
Любое использование материалов допускается только при наличии гиперссылки на cronos.asia.
Подписывайтесь на Telegram-канал Central Asia Cronos и первыми получайте актуальную информацию!



